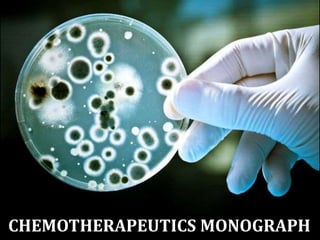
CHEMOTHERAPEUTICS MONOGRAPH
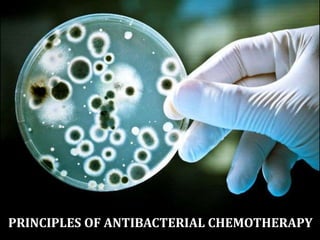
PRINCIPLES OF ANTIBACTERIAL CHEMOTHERAPY

The document provides a comprehensive overview of important bacterial pathogens and the mechanisms of action of various antibiotics, emphasizing the importance of selecting appropriate treatment based on bacterial resistance patterns. It details classifications of bacteria, the roles of different classes of antibiotics, and specific considerations for the use of these medications in neonates. The document also outlines principles for antimicrobial stewardship in neonatal care, including diagnostic strategies and guidelines for initiating and adjusting antibiotic therapy.